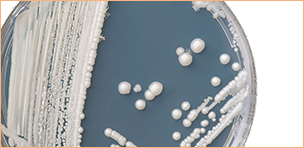

无锡太医堂皮肤病中医院 > 季节高发 > 灰指甲 >
生活中患灰指甲的人越来越多,但是还是有很多的人因为不了解他的病因,导致错过最佳的治疗时间,导致病情加重,不好治疗。那么,灰指甲的病因有哪些呢?
医生解析—灰指甲的病因有哪些?
1、外伤:外伤是诱发灰指甲的重要因素,前来就诊的患者中有一半以上是批(趾)甲有外伤史,且多患有手足癣,仅少数患无手足癣。
2、逆剥:经常是在患者用手撕掉逆剥,指甲受到损伤后,引继发细菌感染或是真菌感染而成为灰指甲。
3、用药:长期服用抗生素,皮质类固醇制剂,免疫抑制剂等,使正常菌群失调,有利于真菌的繁殖而致灰指甲的。

4、化学物质刺激:长期接触汽油、油漆、洗涤剂和强碱性肥皂等质,改变了正常皮肤甲板表面的酸碱度和防御能力,而导致复发。
5、环境因素:气温高、湿度大是灰指甲多发的重要条件。夏季、雨季的灰指甲的发病率比冬季、旱季多且重。因为气温高、湿度大是灰指甲多发的重要条件。
6、个人因素:长期不良卫生习惯是诱发灰指甲的主要病因,如长期穿不透气的鞋袜,使用公用拖鞋、擦脚布、以及男性穿的尖头皮鞋,都对指甲有应该的损伤,这让灰指甲的产生变得容易变形。

名医精解—灰指甲的症状有哪些?
1、甲板混浊:甲真菌病为什么又叫“灰指甲”,就因为真菌入侵甲板或甲床后,大量的真菌繁殖刺激角质物的堆积,使甲板变得混浊、不透明了,给人一种灰蒙蒙的感觉,故而因此得名。
2、变色:这也是灰指甲较为直观的特征,有些引起灰指甲的真菌本身就存在颜色,当真菌繁殖积聚到应该程度颜色就通过病甲表现出来。较为常见的病假颜色有白色、灰色、黄色、褐色等。

3、甲板增厚:除了甲板变混浊之外,甲板增厚也是灰指甲的一大特点。主要因为甲板中的角质物受到真菌的作用而不断堆积,使得甲板增厚,病甲通常比健康指趾甲厚2-3倍以上。
4、甲板变脆易碎:甲板受到真菌的侵入,角质蛋白被角质溶解酶溶解,形成细小的角质颗粒。病甲通常变脆,缺乏韧性容易脱落。
5、增厚:真菌侵入甲板或甲床后,甲板中的角质物受到真菌的作用而高度增殖,角质物的堆积使甲板增厚,甲板的增厚也加深了甲床混浊程度,一般它可以比正常甲板厚出1~3倍以上。、

医生警示—灰指甲带来的危害不容小视
1、导致恶性肿瘤:灰指甲患者可随着搔抓而把真菌感染到身体其他部位,产生新的癣病。灰指甲不但传染、危害皮肤组织,也同样入侵人体内部器官,灰指甲是导致一些恶性肿瘤产生的病因。
2、引起并发症:灰指甲严重时可引起疼痛和不适,指甲一旦受到各种外伤,细菌易于长驱直入,从而引发甲沟炎、甲床炎、手指脓皮病等并发症。
3、产生异常心理障碍:灰指甲患者,常常会有无法摆脱的窘迫感和受挫折感。
医生提醒:无锡太医堂皮肤病中医院医生提醒广大灰指甲患者,灰指甲带来的危害是非常大的,得了灰指甲一定要到正规的医院进行祛除,以免带来更大的危害。

中医渗透软化疗法 疗灰指甲不拔甲
中医渗透软化治疗利用美国尖端奥林巴斯真菌检测仪器准确检测出细菌的形态、数量、颜色、种类,并进行精确定位,运用PC-微电脑药离子导入技术,促进大分子化为小分子,穿透甲板,稳定释放杀菌成份,迅速彻底杀灭潜藏在甲板深层病菌。

中医渗透软化疗法 治疗步骤
1、精准检测真菌:利用美国尖端奥林巴斯真菌检测仪器精准检测,可检查出细菌的形态、数量、种类,并分别进行精确定位。
2、萃取中药直达病灶:我院特制中药成分能直达甲床杀灭真菌,实现了用药更安全更绿色,减少了口服抗真菌类药物用量。

3、封包软化不拔甲:采用软化配方药物将病甲封包,软化除甲的好处在于避免了疼痛,同时能够更彻底的去除掉。

4、红蓝光治疗:QK纳米光波能够快速有效的改善局部血液微循环,促进人体自身免疫系统功能,从而达到间接杀灭真菌的目的。

5、养护结合抗复发:外用生物制剂美甲护指、去腐生肌,配合快速杀灭真菌的同时,修复受损甲床,促进指甲正常生长,预防复发。
【康复案例】无锡太医堂皮肤病中医院治好了我们的灰指甲
王先生灰指甲在我院终治愈

宫先生灰指甲在我院终治愈

孟先生灰指甲在我院终治愈

吴女士灰指甲在我院成功治愈

温馨提提示:无锡太医堂皮肤病中医院医生提醒广大灰指甲患者,得了灰指甲一定要到正规的医院进行治疗,以免带来更大的危害,如果您对灰指甲的病因还有其他的疑问,详情请拨打我院健康热线0510-88815999进行免费咨询。
无锡太医堂注重学科建设,与多家医院开展学科共建、医生双向会诊,汇聚以谭兴隆为首的一大批医生,使无锡太医堂临床诊疗水平得到了很大的提升。


















温馨提醒:预约成功患者,系统会将医生号和医院地址下发到您的手机,请注意查收。